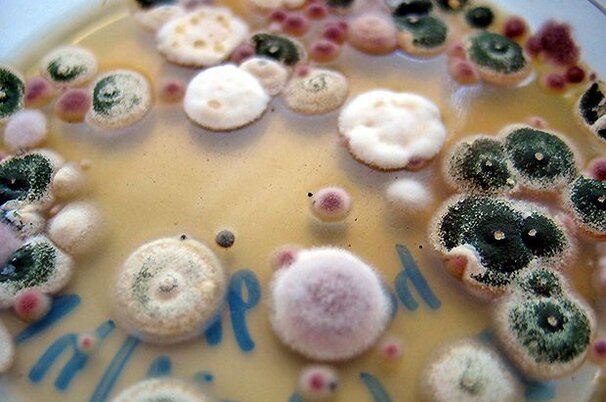

Artikel werden durchsucht.
Vermischtes
Agropreise
Jungen Frauen ein sinnvolles Zwischenjahr anbieten
Vermischtes
Allerlei
Aus: Fast jeder zweite Vogel hat Plastik im Magen
Pflanzen
Forschung
Landwirtschaft: Nützliche Bakterien und Pilze entdecken
Pflanzen
Ackerbau
Globale Getreidevorräte auf höchstem Stand seit 2003
Politik & Wirtschaft
International
S: Unterstützung für Milchbauern gefordert
Politik & Wirtschaft
International
Rus: Ungarn hält an Agrarkooperation fest
Politik & Wirtschaft
Agrarpolitik
Schneider-Ammann wehrt sich gegen «politisch motivierte Hetzjagd»
Pflanzen
Ackerbau
Weizenmehl am Weltmarkt stärker gefragt
Politik & Wirtschaft
International
EU-Milchmarkt droht schwierige zweite Jahreshälfte
Landtechnik
Firmen & Personen
JCB investiert in den Standort Deutschland
Das Wetter heute in
Lesershop
Umfrage

Lässt Ihr Trockenfutter produzieren?
- Ja, aus Gras:0%
- Ja, aus Mais:0%
- Ja, aus Gras und Mais:100%
- Nein:0%
Teilnehmer insgesamt: 2
Bekanntschaften
Suchen Sie Kollegen und Kolleginnen für Freizeit und Hobbies? Oder eine Lebenspartnerin oder einen Lebenspartner?